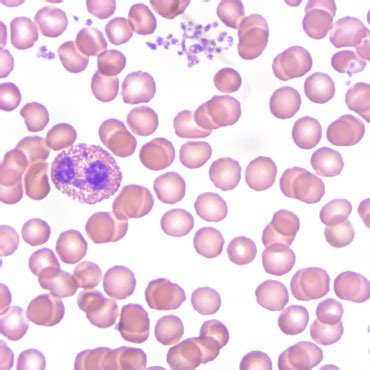
Blastocistos mikroskopinis vaizdas su matoma tuščia ertme (blastoceliu)

Nevaisingumas yra sudėtinga ir dažnai stigmatizuojama problema, su kuria susiduria daugybė porų. Nors statistika rodo, kad net kas penkta pora pasaulyje susiduria su vaisingumo iššūkiais, diskusijos apie tai ir pagalbinio apvaisinimo procedūras vis dar gaubia paslaptis. Šiuolaikinės vaisingumo klinikos neatsiejamos nuo pagalbinio apvaisinimo laboratorijų, kuriose embriologų kruopštumas ir profesionalumas tampa lemiančiu veiksniu, siekiant sėkmingo nėštumo. Šiame straipsnyje gilinsimės į vieną svarbiausių pagalbinio apvaisinimo proceso etapų - blastocistos tuščiosios ertmės formavimąsi, analizuodami jo svarbą, mechanizmus ir įtaką vaisingumo procedūrų sėkmei.
Embriologų Darbo Objektas: Lytinės Ląstelės ir Ankstyvoji Vystymosi Stadija
Žmogaus embrionu laikomas organizmas nuo apvaisintos kiaušialąstės iki aštuntosios vystymosi savaitės, kai jis įgauna žmogui būdingą pavidalą ir tampa vaisiumi. Tačiau pagalbinio apvaisinimo procedūrų kontekste, embriologų dėmesys sutelkiamas į kur kas ankstesnę stadiją - 2-8 nediferencijuotų ląstelių organizmą.
Kaip ir natūralaus apvaisinimo atveju, taip ir gydymo metu, būtinos lytinės ląstelės. Kiaušialąstės gaunamos kiaušidžių punkcijos metu, o spermatozoidai - iš spermos mėginio. Tais atvejais, kai spermoje spermatozoidų nerandama (diagnozuojama azoospermija), daliai pacientų spermatozoidai gali būti sėkmingai paimti tiesiai iš sėklidžių. Svarbu pabrėžti, kad nei kiaušialąstės, nei spermatozoidai nėra dirbtinai sukuriami.
Laboratorijoje Sukuriamas „Pasimatymas“: Kiaušialąstės Apvaisinimas
Tam, kad kiaušialąstė galėtų būti apvaisinta, pakanka ją patalpinti į terpę, kurioje būtų pakankamas kiekis judrių spermatozoidų. Laboratorijoje embriologai imituoja šį procesą. Kitaip tariant, jei moters organizme spermatozoidai neranda kelio pas kiaušialąstę arba jiems netinka aplinka, laboratorijoje sudaromos sąlygos „kiaušialąstės ir spermatozoido pasimatymui“.
Ne visada pavyksta užtikrinti šimtų tūkstančių judrių spermatozoidų buvimą. Kartais tenka dirbti su pavieniais spermatozoidais. Tokiu atveju embriologo užduotis yra kruopščiai atrinkti morfologiškai taisiklingus, pačius judriausius ir fiziologiškai subrendusius spermatozoidus. Vieną, visais atžvilgiais geriausią, spermatozoidą, naudojant ploną adatėlę, mikromanipuliatorių ir, pageidautina, hialurono rūgšties pagalbą, reikia įterpti tiesiai į kiaušialąstės citoplazmą. Ši procedūra vadinama intracitoplazmine spermatozoido injekcija (ICSI).
Visos šios manipuliacijos atliekamos tą pačią dieną, kai gaunamos lytinės ląstelės. Jau kitą dieną tikrinamas kiaušialąsčių apvaisinimas.
Zigota ir Ankstyvasis Embriono Vystymasis: Svarbiausi Kriterijai
Apvaisinta kiaušialąstė vadinama zigota. Zigotos kruopščiai vertinamos. Netrukus zigota pradeda dalintis. Sekančią dieną ji tampa dviejų, vėliau keturių ląstelių embrionu.
Pagrindiniai kriterijai, vertinant embriono vystymąsi antrą parą, yra:
- Ląstelių skaičius: Idealiu atveju, antrą parą embrionas turėtų būti keturių ląstelių.
- Dydžio vienodumas: Ląstelės turėtų būti panašaus dydžio.
- Fragmentacija: Fragmentai yra pašaliniai dariniai, kurie gali atsirasti dėl įvairių priežasčių. Jei jų yra daug, tai nepalankus ženklas tolimesniam embriono vystymuisi.
Šie kriterijai vertinami balais, nuo 1 (žemiausias balas) iki 4 (aukščiausias balas). Idealiu atveju, antrą parą embrionas bus keturių ląstelių, jo ląstelės bus vienodos, o fragmentacija nebūdinga - toks embrionas bus pažymėtas 4(4/4).
Gali būti, kad trečią parą embrionas bus aštuonių ląstelių, jo ląstelės bus lygios, tačiau pasitaikys nedidelė fragmentacija. Tokiu atveju poros embrionas bus pažymėtas 8(4/3).
Kritinis lytinių ląstelių, zigotų ir embrionų vertinimas viso proceso metu priklauso nuo embriologo patirties ir kruopštumo. Į moters gimdą gali būti patalpinami ne tik aštuonių, bet ir keturių ląstelių embrionai, priklausomai nuo situacijos ir specialistų rekomendacijų.
Blastocista: Gyvybės Užuomazga ir Sėkmės Indikatorius
Gana dažnai embrionai auginami ir ilgiau, iki blastocistos stadijos. Blastocista yra ankstyvoji žmogaus vystymosi stadija, kurios metu susiformuoja tuščia ertmė. Ši stadija yra itin svarbi, nes ji leidžia tiksliau įvertinti embriono gyvybingumą ir potencialą sėkmingai implantacijai.
Susiformavusi blastocista turi būti nedelsiant perkeliama į gimdą, nes kitu atveju, neturėdama kur implantuotis, ji žūsta. Jei ji patenka į gimdą, sėkmės atveju implantuojasi.
Auginant embrionus iki blastocistos stadijos, atrenkami patys stipriausi embrionai, nes ne visi embrionai pasiekia šią vystymosi stadiją - dalis jų nustoja vystytis 2-3 parą. Tai reiškia, kad auginimas iki blastocistos stadijos yra papildomas atrankos mechanizmas, didinantis sėkmingo nėštumo tikimybę.
Jei susiformuoja daugiau nei viena kokybiška blastocista, neišnaudotos blastocistos užšaldomos vėlesniam naudojimui.
Veiksniai, Įtakojantys Sėkmę: Nuo Amžiaus Iki Laboratorijos Sąlygų
Vienas svarbiausių veiksnių, įtakojančių pagalbinio apvaisinimo procedūrų sėkmę, yra kiaušialąsčių ir spermatozoidų kokybė. Dažnai tai lemia poros amžius. Vyresniame amžiuje tiek kiaušialąsčių, tiek spermatozoidų kokybė gali suprastėti, o tai mažina apvaisinimo ir sėkmingo vystymosi tikimybę.
Taip pat svarbu tinkamai subalansuota stimuliacija moteriai, siekiant gauti kuo daugiau kokybiškų kiaušialąsčių. Kontroliuojamas kiaušialąsčių paėmimas punkcijos metu, atsakingas ir kvalifikuotas ginekologo bei embriologo darbas yra neatsiejama sėkmės dalis.
Modernios technologijos ir priemonės taip pat atlieka svarbų vaidmenį:
- Aukščiausios kokybės embrionų auginimo terpės: Specialios terpės užtikrina optimalias sąlygas embrionų vystymuisi.
- Specialios lėkštelės: Jų dizainas ir medžiaga gali turėti įtakos embrionų augimui.
- Naujausi inkubatoriai: Palaikantys tinkamą temperatūrą, drėgmę ir dujų koncentraciją, jie sukuria stabilią aplinką.
- Naujos technologijos: Pavyzdžiui, „Time-lapse“ technologija, leidžianti stebėti embriono vystymąsi 24 valandas per parą kompiuterio ekrane, suteikia embriologams daugiau informacijos apie embriono gyvybingumą ir vystymosi eigą.
Time-lapse Incubators
Aplinkos Sąlygų Svarba Laboratorijoje: Švarumas ir Oro Kokybė
Neabejotinai, pagalbinio apvaisinimo sėkmė labai priklauso ne tik nuo specialistų įgūdžių ir modernios įrangos, bet ir nuo aplinkos sąlygų pagalbinio apvaisinimo laboratorijoje. Oro kokybė yra vienas svarbiausių veiksnių, apdorojant audinius ir ląsteles. Ji gali turėti įtakos audinių ir ląstelių užteršimo rizikai. Bakterijos, virusai ir kiti mikroorganizmai gali sąlygoti embrionų žūtį.
Todėl laboratorijų patalpose taikomi aukšti švaros reikalavimai, o oras filtruojamas specialiais Hepa filtrais. Šie filtrai sulaiko itin smulkias daleles, tokias kaip virusai, dujų molekulės ir bakterijos. Tai labai svarbu, nes ląstelių apdorojimas, kurį veikia aplinkos sąlygos, turi būti atliekamas aplinkoje, kurioje užtikrinamas nustatytos kokybės oras ir švarumas, siekiant kuo labiau sumažinti užteršimo riziką. Europoje yra labai nedaug pagalbinio apvaisinimo laboratorijų, kuriose įrengta tokia pažangi ventiliacinė sistema.
Blastocistos Dangalas: Zona Pellucida ir Jos Svarba
Brendimo proceso metu iki blastocistos stadijos, embrionas yra apsaugotas specializuotu apvalkalu, žinomu kaip zona pellucida. Šis apvalkalas, primenantis vištos kiaušinio lukštą, saugo embrioną nuo išorės pavojų.
Tuo metu blastocistą jau sudaro apie 200 ląstelių, ir dėl to jos implantacijos paviršius yra didesnis. Taip pat, dėl šios priežasties, blastocista turi didesnę galimybę sėkmingai implantuotis, palyginti su mažesniu, mažiau išsivysčiusiu embrionu.
Gestacinis Nešiotojas IVF: Alternatyva Tėvystei
Gestacinis nešiotojas IVF, dažnai vadinamas gestacine surogatine motinyste, yra reprodukcinė technologija, leidžianti asmenims ar poroms, negalinčioms pačioms pastoti ar išnešioti nėštumo, susilaukti vaiko. Ši procedūra apima apvaisinimą mėgintuvėlyje (IVF), kurio metu, naudojant numatomų tėvų ar donorų kiaušinėlius ir spermą, sukuriamas embrionas.
Pagrindinis gestacinio nešiotojo IVF tikslas - suteikti kelią į tėvystę toms, kurios susiduria su įvairiais reprodukciniais iššūkiais. Tai gali būti moterys, turinčios sveikatos sutrikimų, neleidžiančių saugiai išnešioti nėštumo, poros, turinčios nevaisingumo problemų, arba tos pačios lyties vyrų poros, norinčios turėti vaikų.
Procedūra paprastai prasideda nuo numatomos motinos arba kiaušialąsčių donorės kiaušidžių stimuliacijos, siekiant pagaminti daug kiaušialąsčių. Šios kiaušialąstės vėliau paimamos ir apvaisinamos laboratorijoje. Kai embrionams išsivysto, vienas ar keli atrenkami perkėlimui į nėštumo nešiotojo gimdą.
Kada Rekomenduojamas Gestacinis Nešiotojas IVF?
Gestacinis nešiotojų IVF rekomenduojamas dėl įvairių priežasčių, visų pirma, kai tradicinis nėštumas nėra perspektyvi alternatyva:
- Medicininės sąlygos: Moterims, turinčioms tam tikrų sveikatos sutrikimų, tokių kaip sunkūs gimdos sutrikimai, lėtinės sveikatos problemos (pvz., širdies ligos ar diabetas) arba pasikartojantys persileidimai, gali būti rekomenduojama naudoti gestacinį nešioklę.
- Nevaisingumas: Poros, susiduriančios su nevaisingumu dėl tokių veiksnių kaip vyresnis motinos amžius, sumažėjęs kiaušidžių rezervas arba vyrų nevaisingumas, gali rasti sprendimą gestacinio nešiotojo pagalba.
- Tos pačios lyties vyrų poros: Tos pačios lyties vyrų poroms, norinčioms tapti tėvais, gestacinis nešiotojas IVF suteikia galimybę susilaukti biologinio vaiko.
- Ankstesnės surogatinės motinystės nesėkmės: Kai kurie asmenys ar poros anksčiau galėjo nesėkmingai bandyti pasinaudoti surogatine motinyste.
- Genetinės problemos: Poros, turinčios žinomų genetinių sutrikimų, gali rinktis gestacinį nešiotojų IVF, kad užtikrintų, jog jų vaikas neturi specifinių genetinių sutrikimų. Prieš perkėlimą embrionams gali būti atliekamas preimplantacinis genetinis tyrimas (PGT), siekiant patikrinti genetinius sutrikimus.
Keletas klinikinių situacijų ir diagnostinių duomenų gali parodyti, kad pacientė yra tinkama kandidatė gestaciniam nešiotojų IVF:
- Gimdos anomalijos: Moterys, turinčios įgimtų gimdos anomalijų, tokių kaip pertvarinė gimda arba gimdos nebuvimas (Mayer-Rokitansky-Küster-Hauser sindromas), gali negalėti išnešioti.
- Sunkios sveikatos būklės: Dėl būklių, keliančių didelę riziką nėštumo metu, tokių kaip sunki hipertenzija, autoimuninės ligos ar tam tikri vėžio tipai, sveikatos priežiūros specialistai gali rekomenduoti gestacinį nešiotojų IVF.
- Pasikartojantis persileidimas: Moterims, patyrusioms kelis persileidimus, gali būti naudingas gestacinis nešioklės IVF.
- Nevaisingumo diagnozės: Poroms, kurioms diagnozuotas nevaisingumas, ypač toms, kurioms dėl amžiaus ar sveikatos sutrikimų sėkmingo nėštumo prognozė yra prasta, gali būti patarta apsvarstyti gestacinį nešiotojų IVF.
- Genetinių tyrimų poreikiai: Poros, turinčios genetinių sutrikimų, gali rinktis gestacinį nešiotojo IVF, kad užtikrintų sveiką nėštumą.
- Tos pačios lyties vyrų poros: Kaip minėta anksčiau, tos pačios lyties vyrų poros dažnai renkasi gestacinį nešiotojo dirbtinį apvaisinimą, kad taptų tėvais.
Apibendrinant, gestacinis nešiotojų apvaisinimas po nėštumo yra vertinga reprodukcinė galimybė asmenims ir poroms, susiduriantiems su įvairiais iššūkiais tėvystės kelyje.
Kontraindikacijos Gestaciniam Nešiotojų IVF
Nors gestacinis nešiotojo dirbtinis apvaisinimas gali būti tinkamas pasirinkimas daugeliui asmenų ir porų, susiduriančių su nevaisingumu, tam tikros būklės ar veiksniai gali padaryti pacientę netinkamą šiai procedūrai:
- Gimdos anomalijos: Moterys, turinčios reikšmingų gimdos anomalijų, tokių kaip įgimti apsigimimai, sunkios fibromos arba kurioms buvo atlikta gimdos operacija, pažeidžianti gimdos ertmę, gali netikti gestaciniam nešiotojų IVF.
- Sunkios medicininės būklės: Asmenims, sergantiems sunkiomis lėtinėmis ligomis, tokiomis kaip nekontroliuojamas diabetas, hipertenzija ar autoimuniniai sutrikimai, nėštumo metu gali padidėti rizika.
- Užkrečiamos ligos: Tam tikros infekcinės ligos, tokios kaip ŽIV, aktyvus hepatitas ar kitos užkrečiamos infekcijos, gali kelti pavojų tiek nėštumo nešiotojui, tiek besivystančiam vaisiui.
- Psichikos sveikatos problemos: Asmenys, turintys negydytų sunkių psichikos sveikatos problemų, gali būti netinkami kandidatai gestaciniam nešiotojų IVF.
- Piktnaudžiavimas medžiagomis: Piktnaudžiavimas veikliosiomis medžiagomis, įskaitant alkoholį, narkotikus ar tabaką, gali smarkiai paveikti nėštumo nešiotojo ir vaisiaus sveikatą.
- Amžiaus veiksniai: Nors vien amžius nėra griežta kontraindikacija, vyresnis motinos amžius (paprastai vyresnis nei 40 metų) gali padidinti su nėštumu susijusią riziką.
- Trūksta paramos: Palaikanti aplinka yra labai svarbi sėkmingai nėštumo nešiojimo patirčiai.
- Teisiniai ir etiniai aspektai: Su surogatine motinyste susiję teisiniai klausimai gali skirtis priklausomai nuo vietos. Asmenys ar poros turi užtikrinti, kad jie laikytųsi vietos įstatymų dėl gestacinių nešiotojų.
Pasiruošimas Gestaciniam Nešiotojų IVF
Pasiruošimas gestaciniam nešiotojų IVF apima kelis svarbius veiksmus, siekiant užtikrinti sklandų procesą:
- Konsultacija su vaisingumo specialistu: Pirmas žingsnis - suplanuoti konsultaciją su vaisingumo specialistu, turinčiu patirties nėštumo nešiotojų IVF srityje.
- Medicininiai įvertinimai: Tiek būsimiems tėvams, tiek nėštumo nešiotojui bus atlikti išsamūs medicininiai įvertinimai. Tai apima kraujo tyrimus, vaizdinius tyrimus ir infekcinių ligų patikras.
- Psichologinis konsultavimas: Psichologinės konsultacijos dažnai rekomenduojamos tiek būsimiems tėvams, tiek būsimai nešiotojui.
- Teisiniai susitarimai: Labai svarbu sudaryti teisinį susitarimą tarp būsimų tėvų ir nėštumo nešiotojo. Šioje sutartyje turėtų būti nurodytos kiekvienos šalies teisės ir pareigos, įskaitant finansinius susitarimus, medicininius sprendimus ir tėvų teises.
- Gyvenimo modifikacijos: Tiek būsimi tėvai, tiek nėštumo nešiotoja turėtų laikytis sveikos gyvensenos įpročių prieš procedūrą.
- Vaisingumo gydymas būsimiems tėvams: Jei būsimoji motina naudoja savo kiaušinėlius, jai gali prireikti kiaušidžių stimuliacijos, kad būtų pagaminti keli kiaušinėliai.
- Embriono sukūrimas: Ištraukus kiaušinėlius, jie bus apvaisinti numatyto tėvo arba donoro sperma.
- Instrukcijos prieš procedūrą: Artėjant procedūros datai, vaisingumo klinika pateiks konkrečius nurodymus.
Žingsnis po Žingsnio: Gestacinis Nešiotojas IVF Procesas
Žingsnis po žingsnio suprantant gestacinio nešiotojo IVF procesą, būsimiems tėvams gali būti lengviau suprasti šią patirtį:
- Kiaušidžių stimuliacija: Jei būsimoji motina naudoja savo kiaušinėlius, jai bus stimuliuojamos kiaušidės, kad būtų pagaminti keli kiaušinėliai.
- Kiaušinių paėmimas: Kai kiaušinėliai subręsta, atliekama nedidelė chirurginė procedūra, vadinama transvaginaline ultragarsine aspiracija, siekiant juos išimti.
- Apvaisinimas ir embriono auginimas: Ištrauktos kiaušialąstės apvaisinamos numatyto tėvo arba spermos donoro sperma. Po kelių dienų stebėjimo atrenkami geriausios kokybės embrionai perkėlimui į gestacinį nešiotoją.
- Embriono perkėlimas: Tai paprasta procedūra, kurios metu plonas kateteris per gimdos kaklelį įvedamas į gimdą, kur įsodinami embrionai.
- Po perkėlimo: Po embriono perkėlimo nešiotojui gali būti patarta trumpam pailsėti.
- Nėštumo stebėjimas: Nėštumui progresuojant, bus aptariami gimdymo planai.
Rizika ir Komplikacijos
Kaip ir bet kuri medicininė procedūra, gestacinis nešiotojų IVF kelia tam tikrą riziką ir galimas komplikacijas:
- Kiaušidžių hiperstimuliacijos sindromas (OHSS): Ši būklė gali pasireikšti moterims, kurioms stimuliuojamos kiaušidės, dėl to gali patinti kiaušidės ir atsirasti diskomfortas pilve.
- Negimdinis nėštumas: Retais atvejais embrionas gali implantuotis už gimdos ribų, dažniausiai į kiaušintakį.
- Daugybinis nėštumas: Nors blastocistų auginimas iki stadijos padeda sumažinti daugybinio nėštumo riziką, ji vis tiek išlieka.
Apibendrinant galima teigti, kad gestacinis nešiotojų IVF yra sudėtingas, bet naudingas procesas, galintis padėti asmenims ir poroms įgyvendinti savo svajonę tapti tėvu.
Atsigavimo Procesas Po Gestacinio Nešiotojo IVF
Atsigavimo procesas po nėštumo nešiotojui IVF (apvaisinimo in vitro) yra labai svarbus tiek nėštumo nešiotojui, tiek būsimiems tėvams:
- Iškart po procedūros (1-3 dienos): Po embriono perkėlimo vaisiaus nešiotoja gali jausti lengvus mėšlungius, tepimą ar pilvo pūtimą. Šie simptomai paprastai yra normalūs ir turėtų išnykti per kelias dienas.
- Pirmoji savaitė (4-7 dienos): Pirmąją savaitę po perkėlimo nėščioji turėtų ir toliau neskubėti. Rekomenduojama lengva veikla, pavyzdžiui, vaikščiojimas, tačiau reikėtų vengti sunkių daiktų kilnojimo ar intensyvaus fizinio krūvio.
- Dvi savaitės po perkėlimo: Nėštumo testas paprastai atliekamas maždaug po dviejų savaičių nuo embriono perkėlimo. Jei testas teigiamas, nešiotoja toliau stebi savo sveikatos priežiūros paslaugų teikėją.
- Nuolatinė priežiūra (3-12 savaitės): Jei nėštumas patvirtinamas, nėštumo nešiotoja reguliariai tikrins nėštumo eigą. Dauguma gestacinių nešiotojų gali grįžti prie įprastos veiklos per kelias savaites, priklausomai nuo individualaus pasveikimo ir sveikatos priežiūros paslaugų teikėjo patarimų.
Privalumai
Nėštumo nešiojimo IVF suteikia daug privalumų tiek būsimiems tėvams, tiek nėštumo nešiotojui:
- Šeimos pastatymo variantai: Asmenims ar poroms, susiduriantiems su nevaisingumu dėl sveikatos sutrikimų, amžiaus ar kitų veiksnių, gestacinis dirbtinis apvaisinimas (IVF) suteikia perspektyvų kelią į tėvystę.
- Sveikesnis nėštumas: Nėščiosios nešiotojos dažnai parenkamos atsižvelgiant į jų sveikatą ir ankstesnę nėštumo patirtį.
- Emocinis palengvėjimas būsimiems tėvams: Nėštumo nešioklės naudojimas gali sumažinti emocinį stresą, susijusį su nevaisingumo gydymu.
- Palaikantys santykiai: Ryšys tarp būsimos nėščiosios ir būsimų tėvų gali skatinti palaikančią aplinką.
Kaina ir Priklausomumas Nuo Ligoninės
Nors gestacinis nešiotojo IVF yra populiarus pasirinkimas, svarbu suprasti, kaip jis lyginamas su tradicine surogatine motinyste. Vidutinė gestacinio nešiotojo IVF kaina Indijoje svyruoja nuo 1,50,000 3,00,000 iki XNUMX XNUMX ₹. Ligoninės taiko skirtingas kainodaros struktūras. Pavyzdžiui, „Apollo“ ligoninėse teikiama pirmenybė skaidriam bendravimui ir individualiems priežiūros planams. „Apollo“ ligoninės laikomos viena geriausių gestacinio apvaisinimo ligoninių Indijoje dėl patikimos patirties, pažangios infrastruktūros ir nuolatinio dėmesio pacientų rezultatams.
Po Embriono Perkėlimo: Rekomendacijos
Po embriono perkėlimo svarbu laikytis tam tikrų rekomendacijų:
- Mityba: Palaikykite subalansuotą mitybą, gausią maistinių medžiagų. Sutelkite dėmesį į visavertį maistą, įskaitant vaisius, daržoves, liesus baltymus ir neskaldytus grūdus. Taip pat labai svarbu gerti pakankamai skysčių.
- Fizinis aktyvumas: Po embriono perkėlimo paprastai rekomenduojama atlikti lengvą fizinį krūvį, pavyzdžiui, vaikščioti. Tačiau bent savaitę venkite sunkaus fizinio krūvio, sunkių daiktų kilnojimo ir didelio intensyvumo treniruočių.
- Poilsis: Rekomenduojama po embriono perkėlimo pailsėti bent 24-48 valandas.
- Mėšlungis: Po embriono perkėlimo dažnai pasireiškia lengvas mėšlungis, kuris paprastai išnyksta per kelias dienas.
- Vaistai: Jūsų sveikatos priežiūros paslaugų teikėjas gali skirti vaistų, tokių kaip progesteronas, nėštumui palaikyti.
- Nėštumo testas: Nėštumo testas paprastai atliekamas maždaug po dviejų savaičių nuo embriono perkėlimo.
- Emocinė parama: Emocinę paramą galima gauti iš įvairių šaltinių, įskaitant konsultavimo paslaugas, paramos grupes ir pokalbius su draugais bei šeima.
- Kelionės: Paprastai patartina vengti tolimų kelionių bent savaitę po embriono perkėlimo.
- Neigiamas nėštumo testas: Jei nėštumo testas neigiamas, svarbu leisti sau išgyventi gedulą ir apdoroti emocijas.
- Teigiamas nėštumo testas: Jei nėštumas patvirtinamas, pasiruoškite reguliariai tikrindamiesi, palaikydami sveiką gyvenimo būdą ir aptardami visus rūpesčius su savo sveikatos priežiūros paslaugų teikėju.
Rizika ir Amžiaus Ribos
Kaip minėta, rizika gali apimti IVF procedūros komplikacijas, tokias kaip kiaušidžių hiperstimuliacijos sindromas (KHSS), ir galimus emocinius iššūkius tiek nešiotojui, tiek būsimiems tėvams. Daugumoje klinikų yra nustatytos nėštumo nešiotojų amžiaus ribos, paprastai nuo 21 iki 40 metų. Jei turite sveikatos sutrikimų, būtina juos aptarti su savo sveikatos priežiūros paslaugų teikėju.
Lyties pasirinkimas paprastai nėra gestacinio nešiotojo IVF proceso dalis, nebent yra konkrečių medicininių priežasčių. Kilus komplikacijų, sveikatos priežiūros komanda suteiks tinkamą medicininę pagalbą.
Renkantis gestacinį nešioklę, reikia atidžiai apsvarstyti sveikatą, emocinį pasirengimą ir suderinamumą. Teisiniai susitarimai yra labai svarbūs susitarimuose dėl nėštumo nešiojimo, kuriuose apibrėžiamos abiejų šalių teisės ir pareigos. Teisiniai susitarimai paprastai išsprendžia tėvų teisių klausimą, užtikrindami, kad būsimi tėvai išlaikytų tėvų teises.
Nėštumo metu atliekamas dirbtinis apvaisinimas (IVF) yra transformuojanti galimybė asmenims ir poroms, siekiantiems sukurti savo šeimas. Tai suteikia kelią į tėvystę, kartu užtikrinant tiek nėštumo nešiotojo, tiek kūdikio sveikatą ir gerovę. Jei svarstote apie šią procedūrą, būtina pasikalbėti su medicinos specialistu, kuris gali padėti jums visame procese ir išspręsti visus jūsų rūpesčius.